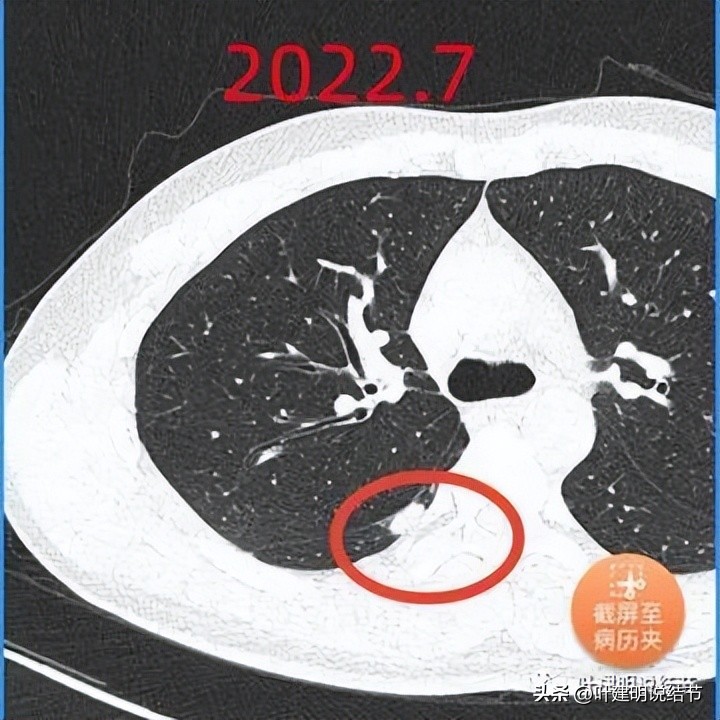
肺部结节医生建议抗炎后复查,放射科医生查出肺结节

网络咨询病例:

前言: 今天是第五个医师节,但因为近日湘雅二院的事情闹得沸沸扬扬,医患关系可能再次遭遇危机,心情怎么也高兴不起来。医疗系统与其他系统一样当然都会有这样那样的问题,人性也本来就是复杂的,但医疗与每一个人戚戚相关,所以更容易引起共鸣与关注。医生的“医者仁心·敬佑生命·救死扶伤·大爱无疆”说起来轻松、做起来太难!医生的人生观、世界观;事业心强弱;家庭因素;生活成本经济因素;晋升科研压力;医保控费压力;经济效益考核;同行同事竞争…,医生也是普通人,也有柴米油盐酱醋茶,但医生的职业要求医生是不食人间烟火的圣人。有人会成魔,也有的些许瑕疵会无限放大…,唉医路难:当医生容易(谋职),成为医生难(从业)。当然,医疗的乱象该说的还是要说,不能捂着,掩盖问题并不能解决问题,还是仍要让公众认识到,也让主管部门了解,并从根源上、机制上、考核设计上进行改革。我想不可能坏人都集中到医疗行业,如果某个行业有许多不尽人意之处,总该是某些更深层次的方面需要修正。前路漫漫,且行且珍惜!我想,只能尽量做好自己,不忘初心。

正文:
基本信息: 男 54岁 山东人
曾就诊医院: 山东某省级医院,山东某县人民医院
疾病描述: 患者为某县人民医院麻醉科医生,2022年5月8号,全院做5mmCT平扫普查时发现肺部结节。6月8号去某省医院复查,发现结节增大。医生建议吃消炎药。吃了三盒西他沙星 ,6月23号去该医院复查,发现部分结节增大,(新出现一个大的结节)部分变小。胸外科专家和呼吸科专家均倾向于特殊感染。胸外科建议打一周吊瓶:左氧氟沙星加头孢;呼吸科建议做增强CT活检,来确定是结核感染还是其他感染。进行皮试和抽血,检查结果排除结核感染。抽血检查,真菌感染成阴性。看过的专家均考虑炎症可能性大,但没有查出感染原因。请您帮助解决一下疑惑:1.请您给出您的病情病因诊断;2.看过的专家均考虑最大的可能是炎症,但检查结果均为阴性。还有未考虑到的感染情况吗?3.下一步应该怎么办?请给出具体详细的建议。
影像展示分析与意见:
先来看5月初的:

左肺淡磨玻璃结节,轮廓较清,似有微小血管走向病灶

右中叶心膈角处实性斑片状影,密度较高,周围有卫星灶,与胸膜近但没有侵犯,也没有牵拉,当然也未见相应胸膜水肿增厚(炎性改变)

左肺底实性结节,似纤维增生或慢性炎
影像初印象:
桔色圈起来的像不典型增生,并有微血管进入,需要关注随访;蓝色圈起来的像局部慢性炎;绛红色圈起来的密度过高,又在边缘,还有卫星灶,感觉是慢性炎或纤维增生,没什么风险。
再看6月初的:

左侧的痰磨玻璃结节没什么变化

右中叶的病灶居然增大了!,卫星灶被它包进去了,感觉整体膨胀性更明显了,与胸膜间的间隙缩小了,当然仍是没有牵拉的。

左肺底的没有什么变化
影像再判断:
桔色圈起来的密度甚低,应该没到不典型增生;蓝色圈起来的变化不显著;绛红色圈起来的有所增大,边缘略糊,卫星灶被主病灶包进去了。桔色圈起来的先不管,绛红色圈起来的怎么会1个月内进展呢?肿瘤?收缩力缺乏。普通炎症?没有症状。肉芽肿性炎或隐球菌可以。
最后看7月份的:

右肺底新增实性微小结节,轮廓清楚,密度高

中叶病灶进一步增大进展,圆形或类圆形,但收缩力不明显,没有对胸膜或叶间裂造成牵拉影响

右中叶新增微小实性轮廓清楚的结节
右下叶背段新增实性结节,感觉不太硬,因为只延着叶间裂与胸壁之间生长,偏向椭圆形。如果质硬的肿瘤性质不可能这样,肯定是膨胀性生长,会推压周围组织或牵拉胸膜。所以这样的病灶容易是炎症性的。

左肺底病灶也较这前明显了点起来

左侧淡磨玻璃结节与前相仿

左下叶背段新增微小实性结节,边界清,同样是乏收缩力与膨胀性的
影像终判断:
桔色圈起来的密度很低,边缘显糊,考虑局部慢性炎,或伴肺泡上皮增生可能性大;绛红色圈起来的略有进展;蓝色圈起来的略有进展;问题是出现了许多红色圈起来的实性结节。肿瘤不可能这样,多原发的多为磨玻璃结节,实性的罕见,而且进展太快也不符合。结核?相关检查阴性,也不符合上叶或下叶背段多见的通常好发部位。普通炎症当然也不好解释。所以仍回到特殊感染:我是外科医生,特殊的内科感染的并不熟悉,但隐球菌在外科切下来化验里并不少见。而且符合影像表现、发展速度、年纪情况、临床症状不明显等各方面。血检阴性是否能排除?请咨询内科医生,但我想影像上不能除外。如果试验性抗结核,还不如试验性抗隐球菌的治疗。当然如果同意CT引导下穿刺活检也可以。
总体意见:
两肺多发结节,大部分为实性,抗炎治疗复查无好转,反而增多增大进展;但影像表现缺乏膨胀性,也无收缩力,发展过快,没有恶性影像特征,感觉不像恶性像感染性,隐球菌需重点考虑。随访进展(增大增多)即便没有症状也要搞明白,并有针对性治疗。穿刺可考虑,手术暂不建议。以上意见供参考!

(此处已添加医疗卡片,请到*今条头日**客户端查看)